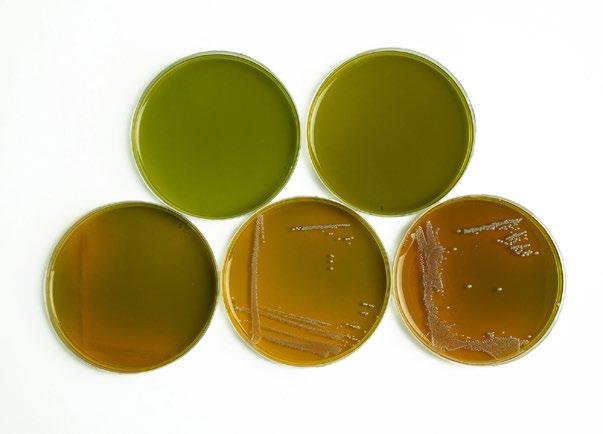

BRAUEREI
Periodical for Breweries, Malt Houses, the Beverage Industry and Partners
















![]()
Periodical for Breweries, Malt Houses, the Beverage Industry and Partners
















The HIC-ESP ion chromatograph, akin to Shimadzu HPLCs, guarantees dependable results in ion analysis with minimal carry-over and precise injection. Its new low-volume anion suppressor ensures high sensitivity and stability over time, while its compact design optimizes lab space usage.
High sensitivity, reliability and robustness through use of the new patent-pending ICDS-40A anion suppressor
Outstanding performance in a compact design with optimized solvent delivery, low carry-over and fast injection speeds
Seamless integration with LabSolutions software platform simplifies analysis settings, data processing/review and reporting while ensuring data integrity




Tianxiao Xu from China has just completed the VLB Certified Brewmaster Course 2025. In an interview, he stated that China is an emerging market with a growing appreciation for quality beer.
is
initiate its brewing activities

On June 27, 2025, 24 graduates received their Certified Brewmaster certificates during a festive ceremony. Dr. Josef Fontaine thanked everyone involved for their outstanding commitment
Dr. Björn Klotzbücher took over the position of VLB's Managing Director in July 1, 2025. As of October 2025, Klotzbücher will officially succeed Dr. Josef Fontaine
As announced on 20 May 2025, Dr. Björn Klotzbücher assumed his position as the new Managing Director of VLB Berlin on 1 July 2025. He succeeds Dr. Josef Fontaine, who will step down from this position at his own request in October 2025. The areas of finance, IT, human resources and research will remain under the responsibility of the previous Managing Director, Gerhard Andreas Schreiber (CFO).
(oh) After his first official public appearance at the VLB summer party on 4 July, Björn Klotzbücher introduced himself to the VLB staff at a company meeting on 11 July.
Björn Klotzbücher (46) was born in the Black Forest and has extensive experience in the brewing and beverage industry. He gained his first practical experience at a local brewery while still at school. After two years in the navy and several internships at other breweries, he began studying brewing and beverage technology at the Technical University of Munich in Weihenstephan in 2001, graduating with a degree in engineering in 2007.
Björn Klotzbücher then worked as a research assistant to Prof. Dr. Werner Back, where he obtained his doctorate in 2010 with a thesis on ‘Lactic acid fermentation of legume protein extracts with the
aim of improving taste’. Klotzbücher started his career in the beverage industry in 2009 at Mitteldeutsche Getränkeindustrie (MEG) in Weißenfels, Saxony-Anhalt. He started as an assistant to the management and went on to hold various management positions with a focus on the further development of the bottling technology there and the establishment of a closed recycling loop for PET.
In 2016, he returned to the brewing industry: as operations manager and authorised signatory at the Herrenhausen private brewery in Hanover, he was not only responsible for production processes there until June 2025 and also managed the private label business of the Wittingen private brewery, which belongs to the same group of owners.
Björn Klotzbücher is an active member of several industry or-

ganisations, including the German Brewers' and Maltsters' Association (DBMB), the Association of Former Weihenstephan Students (VeW) and the Society for the History of Brewing (GGB). He is married and has two children.
The decision to join VLB Berlin was not a difficult one for him: “The VLB is an indispensable source of talent and ideas for our industry. I particularly appreciate its close links to the brewing and beverage industry. I am very much looking forward to working with the entire staff and alongside Gerhard Andreas Schreiber to actively and successfully shape the future of the VLB.”
Transition period until the General Meeting on 6 October 2025
The handover of management from Josef Fontaine to Björn Klotzbücher will take place gradually until the next VLB general meeting on 6 October 2025. Fontaine will then remain with the VLB for another two years as a ‘brand ambassador’. In this role, he will represent the VLB at events and trade fairs and act as a contact person for members. He will also continue to serve on the VLB Administrative Board in an advisory capacity and support the VLB management at the interface with the TU Berlin and the Berlin Senate Administration. Ulrich Rust, Chairman of the VLB Administrative Board, said: “We would like to thank Jupp Fontaine for his outstanding work and his many years of tireless commitment to the VLB. I am also delighted that he will remain with us for another two years in his new role as brand ambassador. In Dr. Björn Klotzbücher, we have found an excellent successor who will continue the successful development of the VLB. This change is an important step towards securing the long-term future of our institute.”
On July 1, 2025, Martin Dubrowsky took over the position of International Sales Manager at the Versuchs- und Lehranstalt für Brauerei in Berlin (VLB). He succeeds Roberto Biurrun, who has left the VLB at his own request after ten years to take on a new professional challenge at Jürgen Löhrke GmbH.
(oh) Martin Dubrowsky is a trained brewer and graduate brewing engineer (TU Berlin). After initial positions at Hasseröder Brauerei and Riha Wesergold in Germany, he spent more than two decades in management positions in the international brewing and beverage industry – including at Namibia Breweries, Polar (Venezuela), Diageo (Ireland and Cameroon), Skol Brewery (Rwanda) and most recently at beverage producers in Nigeria and Ghana. With his move back to Germany, Martin Dubrowsky will assume
responsibility for supporting selected international customers and members at VLB. He will also be responsible for organizing key international VLB conferences, including the Ibero-American Symposium, the Bangkok Brewing Conference and the Africa Brewing Conference.
“We are delighted that we have been able to fill this key position without interruption. With Martin Dubrowsky, we have gained a colleague with excellent international connections and technical expertise, who will continue to develop our global activities for the benefit of our customers and members,” says VLB Managing Director Dr. Josef Fontaine. “At the same time, we would like to thank Roberto Biurrun

Martin Dubrowsky (l.) and VLB Managing Director Dr. Josef Fontaine at the Africa Brewing Conference in Johannesburg, South Africa, in June 2025
for his great commitment over the past ten years and wish him every success in his future career.”

Current trends and innovative hop products come together to deliver unique and surprising taste experiences: Discover new hop varieties, advanced liquid hop technology, and creative nonbeer recipes that can inspire fresh ideas and opportunities for your business.


















































Handing over the VLB membership certificate at the Lion Innovation Centre in Sri Lanka on August 22, 2025: Arno Matthe, Senior Vice President and Brewmaster, Chathura Dissanayake, Chief Supply Chain Officer, Chathura Amarapriya, Senior Vice President Brewing & Planning, Jan Biering (VLB Berlin) and Nirmala Chathuranga, Manager Brewing
Lion Brewery (Ceylon) PLC, Sri Lanka’s market leader, has joined Versuchs- und Lehranstalt für Brauerei in Berlin (VLB), Germany, as its newest member, effective July 2025.
(oh) VLB Berlin, one of the world’s leading centers for brewing science and education, is proud to welcome Lion Brewery (Ceylon) PLC into its international community.
The roots of Lion date back to 1881, when one of the first commercial breweries in Ceylon was established. Throughout the 20 th century, the company grew steadily through expansion and innovation.
In 1996, the brewery was renamed Lion Brewery (Ceylon) PLC following strategic investments from Carson Cumberbatch PLC, one of Sri Lanka’s largest conglomerates, and the Danish Carlsberg Group. Today, Lion Brewery is listed on the Colombo Stock Exchange, with Ceylon Beverage Holdings PLC (part of the Carson Cumberbatch Group) as its major shareholder. The company employs around 360 people and generates

an annual turnover of approximately € 350 million. Lion operates a stateof-the-art brewery in Biyagama, near Colombo, with an annual production capacity of 2 million hl. In December 2024, the company further advanced its innovation drive with the launch of the Lion Innovation Center for Craft Brews, a dedicated hub for the research and development of specialty beers to meet the evolving preferences of consumers. Lion Brewery is the undisputed leader of Sri Lanka’s beer industry. Beyond its home market, the company has steadily expanded its global presence, and today Lion beers are available in more than 15 international markets, including Africa, the Middle East, Europe, and Canada.

The company’s wide-ranging portfolio is produced under the Lion, Carlsberg, and Guinness master brands. Its flagship Lion range includes Lion Lager, Lion Stout, and Lion Strong, along with Carlsberg and Guinness brewed locally for Sri Lanka and the Maldives. The latest chapter at Lion is its Craft range, which reflects the rhythm of the island, the richness of its culture, and the evolving tastes of both locals and visitors.
“Joining VLB Berlin is a significant milestone in Lion Brewery’s journey of innovation and global collaboration. With over 140 years of heritage, we are eager to engage with VLB’s expertise in brewing science and education, while sharing our own experiences. This partnership will support knowledge exchange, research, and innovation as we expand through our new Lion Innovation Center. Our ambition is to strengthen Lion’s role as Sri Lanka’s market leader and a respected global brewer, bringing the character of Lion beers to more consumers worldwide,” stated Chathura Amarapriya, Senior Vice President Brewing & Planning, Lion Brewery (Ceylon) PLC.
VLB is very pleased about strengthening the cooperation: “It is a special honor for us to welcome Lion Brewery from Sri Lanka to our international VLB network,” says VLB Managing Director Dr. Josef Fontaine. “The company has a very ambitious and highly professional approach to brewing and innovation. We are proud to support Lion in its further development and look forward to a fruitful cooperation.”
The VLB membership certificate was handed over to the Lion team by VLB Senior Consultant Jan Biering during his working visit to Colombo in August 2025.

1:
Microbiological samples tested at VLB in 2024, categorised by product groups
VLB Berlin has been one of the leading institutions for research, services, and continuing education in the brewing and beverage industry for over 140 years. An important part of its comprehensive range of services is the microbiological service at the VLB Research Institute for Biotechnology and Water. In addition to a wide range of classic cultural analyses and molecular biological procedures, these services also include support for individual questions and advice on acute microbiological challenges.
Selected microbiological tests are carried out in accordance with DIN EN ISO/IEC 17025:2018 (DAkkS No.: D-PL-14173-01-00). Regular audits and optimizations by our quality management team guarantee independent testing in accordance with the highest standards.
Microbiological focus areas and findings 2024
Breweries, mineral water producers, and other beverage manufacturers in particular continued to use this service for independent external quality control in 2024. In the beverage industry, a variety of microorganisms can seriously and permanently reduce product quality. These microorganisms include bacteria, yeasts, and molds. Contamination is possible throughout the entire production chain. Accordingly, samples from all stages of the manufacturing process were analyzed using a wide range of microbiological tests. In the brewing sector, the focus was on routine checks for beer-spoilage germs such as wildtype yeasts and lactic acid bacteria in tank samples and product testing after bottling, either as a final check before delivery or as part of marketability certificates for trade. In the event of microbiological problems, samples were examined as part of vulnerability analyses and step controls for hygiene monitoring in

order to investigate the causes. In addition to process water and swab samples, attention was also paid to the microbiological examination of filter aids, crown caps, and cleaned bottles. Furthermore, breweries sent in findings (e.g., on agar plates) for the identification of microorganisms present. For a more accurate risk assessment of possible contaminants, microbiological analyses are usually carried out using cultural methods in the first step. Culturable and living contaminants can be detected on different culture media by membrane filtration, plating, or liquid enrichment. There is certainly no “univer-
sal” medium for the detection of beer-spoilage bacteria, and many factors can influence the analysis. These include, among others:
Initial concentration of viable microorganisms
Incubation time
Incubation temperature
Aerobic and/or anaerobic environmental conditions
Composition of the medium.
VLB-S7-S culture media have proven to be reliable and specific for the detection of Gram-positive microorganisms harmful to beer. Beerspoilage Lactobacilli and Pediococci usually show clear colony formation

and color change on VLB-S7-S agar after just 4 days. The growth of accompanying microbiota such as culture yeast and Enterobacteriaceae is suppressed.
If there are indications of possible findings and contamination, e.g., due to growth in the cultural analyses, further identifications can be carried out. The faster reliable statements about the microorganisms present are available, the faster appropriate actions can
be initiated in the company in the event of findings. The equipment available at the VLB allows speciesspecific identification to be carried out as quickly as possible using various PCR systems and MALDI-ToF (Matrix-Assisted Laser Desorption / Ionisation Time of Flight). Real-time PCR kits are used to detect and, in some cases, quantify a wide range of beverage-spoilage microorganisms at the molecular biological level. Furthermore, the use of specific

primers allows the direct detection of specific beer-spoilage microorganisms (e.g., diastatic Saccharomyces cerevisiae). For general and non-targeted identification, PCR methods with universal primers are used. The subsequent sequencing of the PCR product and comparison of the sequences in reference databases enables a reliable statement to be made about the microorganisms present. Another helpful tool for microbial identification

SoftShot® FLEX : Maximum yield through efficient solids separation and flexible adaptation to different beer styles
Brewer Control: User-friendly process control with consistent quality, clear parameters and automated recipe management
LongLife Concept : Maximum life, minimum wear, easy maintenance and reduced operating costs


Figure 3: VLB-S7-S agar plates
Top line: uninoculated agar plates.
Bottom line: inoculated and incubated VLB-S7-S agar plates, from left to right: Pd. damnosus, Lb. lindneri, Lb. brevis.Two parameters of growth can be observed: 1. formation of colonies, 2. production of lactic acid visible by the color change of the medium from green to yellow
is the analysis by MALDI-ToF and matching generated mass spectra against validated microbial reference spectra in databases. Provided that pure cultures are available, e.g., from cultural processes, this identification method can be used to determine many germs within a few minutes due to the simple processing method and fast measurement time.
I n the samples from the brewing environment examined at the VLB in 2024, 5% of the samples showed microbiological abnormalities in terms of beer-spoilage bacteria and 6.5% of the samples showed evidence of wild-type yeasts when using the analytical procedure described above.
identification of microorganisms in their own company laboratories with a comprehensive range of culture media. The VLB's biological laboratory produces a selection of special detection media that are used worldwide in the analysis of beer, wort, and water. Both filtered and unfiltered samples can be tested for microorganisms capable to survive and spoil to beer and beverages. This means that, with correctly applied step-by-step control, the process flow in the plant can be monitored accurate and smooth quality assurance can be guaranteed. VLB culture media are produced to customer order, filled into 250 ml PVC bottles and are therefore ready for use. The production and quality testing of VLB culture media is carried out in accordance with and in compliance with the requirements of DIN EN ISO 11133:2020-10. All batches produced are tested accordingly with organisms from the VLB strain collection and isolates from practice (wild strains) before shipment. Laboratories that use VLB culture media can make their work processes more efficient, as many steps in the production and testing of culture media can be reduced and a consistently high quality is ensured without the risk of deviations in the recipe or errors in the production
of their own media. When stored properly, the shelf life of unopened bottles is 6 to 12 months.
Below is a brief overview of selected culture media.
Standard I Agar is a simple, complex medium generally used for the detection and enumeration of aerobic, mesophilic, heterotrophic bacteria.
Wort Agar is a complex medium for the general detection of yeast, mold, and some bacteria, such as acetic acid bacteria.
Lysine agar is a minimal and selective medium for the detection of non-Saccharomyces wild-type yeast. The growth of culture yeast is suppressed.
Crystal violet agar is used for the detection of Saccharomyces wild-type yeast. It is a selective wort-based medium suppressing the growth of culture yeast for a defined time.
Copper sulfate agar is a complex, selective medium usable for the detection of both Saccharomyces and nonSaccharomyces wild-type yeast. Copper suppresses the growth of culture yeast.
Orange serum agar is a complex medium used to detect acidtolerant and acidophilic microorganisms commonly found in beer mixtures, non-alcoholic beverages, soft-drinks, wine, and wine products.
VLB-S7-S agar and broth are selective indicator media used for the detection of Gram-positive,
photos: ew
Selection of VLB culture media.
Top row, from left to right: VLB-S7-S broth and VLB-S7-S agar; bottom row: wort agar, copper sulphate agar, lysine agar, OFS agar and crystal violet agar
A significant proportion of these were microorganisms with direct beer spoiling potential.
The VLB supports breweries and beverage manufacturers that focus on the cultivation, reliable cultural detection, and

Overview of nutrient media offered by VLB Target
Wort – Agar Yeast and mold
Crystal Violet – Agar
Copper Sulphate – Agar
Lysine – Agar
OFS – Agar
Culture Media for Bacteria
Standard I – Agar
Standard I – Agar + Cycloheximide
OFS – Agar
VLB-S7-S – Agar and Bouillon
beer-spoilage bacteria (Lactobacilli and Pediococci).
The team of the VLB Microbiological Laboratory is available to provide information on our comprehensive range of microbiological analysis services, the supply of culture media, and their specific applications.
Contact:
+ Dr.-Ing. Martin Hageböck, m.hageboeck@vlb-berlin.org
+ Dipl.-Ing. Sandra Dounia biolab@vlb-berlin.org
Saccharomyces wild-type yeast
Saccharomyces and non-Saccharomyces wild type yeast
Non-Saccharomyces wild-type yeast
Acidtolerant and acidophilic yeast and mold
Target
Aerobic mesophilic, heterotrophic bacteria
Aerobic mesophilic, heterotrophic bacteria
Acidtolerant and acidophilic bacteria, e.g., lactic and acetic acid bacteria
Gram-positive, beer-spoilage lactic acid bacteria
Are you looking for an intensive yet comprehensive training programme in applied industrial microbiology? Would you find collaborative learning with international colleagues more advantageous than independent study via computer or textbook?
If so, consider our five-day seminar on 'Applied Microbiology' ! Through laboratory exercises and comprehensive lectures, you will develop skills in microbial methods such as isolation and cultivation of microorganisms on different media, as well as the characterization and handling of contaminants. Next course: 17-21 November 2025 in Berlin. In English.
Information & registration: www.vlb-berlin.org/en/microbiology
Expertly engineered solutions for a diverse beverage market



Conventional pallet-load compression test with 40 boxes and 2400 kg concrete weight as reference measurement
Paul Rothe, Florian Heukäufer, Ingo Pankoke
VLB Research Institute for Management and Beverage Logistics – Testing Laboratory for Packaging
A proven test method for evaluating the long-term stability of reusable beverage crates is the pallet-load compression test. Since the previous method is relatively time-consuming and resourceintensive, an optimized test method was developed within the EFoPa research project at the VLB Berlin Packaging Testing Center. This enables a quick and efficient evaluation of stability.
The growing demand for sustainable packaging solutions is leading to increased use of reusable packaging in the beverage industry. In particular, the use of glass bottles, which are heavier than reusable PET bottles, places greater demands on the stability of load units during transport and storage. A proven test method for evaluating the long-term stabil -

ity of reusable beverage crates is the pallet-load compression test, as described in the Annex to the Special Technical Delivery and Purchase Conditions (STLB). However, this method is time-consuming and resource-intensive. Therefore, as part of the EFoPa research project, an optimized test method was developed at the VLB Berlin packaging testing center, which now enables fast and efficient evaluation.
The traditional pallet-load compression test simulates real storage conditions by applying a defined load to a complete load unit with up to 40 crates over a period of 21 days. During this time, the compression is measured and the crates are examined for structural deformation or damage. However, this method, as described in STLB Annex 7, has several disadvantages. On the one hand, the test duration is very long, with a test time of three or four weeks, thus delaying the development of new crate systems and injection molds. On the other hand, a large amount of space is required, as a complete test setup takes up to 9 m² of floor space. Furthermore, manual measurement of compression using tape measures and calipers is error-prone, time-consuming, and requires experienced personnel. A large number of test samples are required for testing within the framework of STLB. Since
this is a destructive test, 40 additional crates must be supplied. These challenges highlight the need for a more efficient test method that delivers comparable results with reduced time, space, and material requirements.
Development of the accelerated pallet-load compression test
The aim of the EFoPa project was to develop an optimized test procedure that enables accelerated yet precise evaluation of crate stability. The newly developed test, called “Mini-PLT,” is based on the finding that the greatest deformation or compression occurs in the first few hours after the load is applied. By extrapolating the first measured values using the least squares method, long-term deformation can be reliably predicted without waiting for the entire test duration.
The most important features of the new process are outlined below. The number of test samples can be reduced because, instead of 40 crates stacked in eight columns of five, only six crates are stacked in two columns of three on a specially developed base. A specially designed pressure head simulates the real loads of an entire pallet and transfers the test force specifically to the relevant contact surfaces of the crates. In order to record the deformation development in detail, the stack height and compression are measured after
one hour, after 24 hours, and after seven days. After the measurement on day 7, the stack is unloaded, and on day 8 the residual compression is measured 24 hours after unloading. Mathematical modeling using a logarithmic function allows the measured compressions to be extrapolated to a 21-day load duration. These adjustments allow the load duration to be shortened to seven days and the space requirement to be reduced to 3 m².
A special test bench was developed for the implementation of the new test procedure. The central component is an asymmetrical pressure head that replicates the typical load distribution of a pallet and transfers the test force precisely to the normal contact surfaces on the crates. The compression is recorded digitally using high-precision sensors from an optical-tactile measuring system, which detects even the smallest deformations and enables a detailed analysis of the load distribution within the crate columns. A 3D coordinate measuring system (model: XM-5000) from Keyence is used for this purpose. Unlike conventional hand tools such as calipers or tape measures, which only allow one-dimensional measurements, a 3D coordinate measuring machine allows precise measurements in all three spatial directions (X, Y, and Z). A larger number of measuring points can be recorded over a larger area on the crate in order to map the surface and check for warping and bending.
The data collected in the test series show that the most significant deformations occur within the first 24 hours and that the deformation curve then flattens out. This confirms the assumption that reliable long-term forecasts can be made on the basis of earlier measurements.
A direct tabular comparison between the traditional pallet-load compression test and the Mini-PLT illustrates the advantages of the new method: The Mini-PLT thus enables a reduction in test duration of up to 75%
and significantly reduces resource requirements. The economic advantages are manifold. Fewer test samples and shorter test times significantly reduce material, storage, and labor costs. The reduced space requirements allow for decentralization of testing, enabling testing laboratories to use the method more efficiently. For crate manufacturers, it enables accelerated product development, as new crate types can be tested for stability more quickly, thereby accelerating their market launch.
Based on the research results, a patent application was filed (DE102024127739), which covers both the methodological approach and the technical design. In the long term, the Mini-PLT could establish itself as the new standard for stability testing of reusable beverage crates and be included in relevant standards. Discussions will be held with the German Industry Associations Deutscher Brauer-Bund and pro-K to this end.
The EFoPa research project shows that combining precise measurement of experimental data using Keyence's 3D coordinate measuring system with the application of mathematical models enables significant improvements in the stability testing of beverage crates. The Mini-PLT provides a method that is faster, more space-efficient, and more accurate than conventional tests. The findings can be further developed in the future to integrate climatic influences or different pallet designs into the testing process, for example. The research project was funded by the Federal Ministry for Economic Affairs and Climate Protection on the basis of a resolution by the German Bundestag (Funding Code: 49MF220230). The results of this research
Comparison of conventional and optimized pallet-load compression tests
Measurement methodology manually (measuring tape) digitally (visually tactilel)
not only offer economic advantages for the beverage industry, but also contribute to sustainability by making more efficient use of testing resources.
Contact: packaging@vlb-berlin.org

How solid is your expert knowledge when it comes to beer brewing? Whether craftsmanship or extensive expertise in the field of microbiology and food chemistry, a brewer needs the knowledge and overview of the entire manufacturing process. In this issue, we have collected some questions that are part of the basic knowledge of a professional brewer.
1. During the malting process, the water content in the grain initially rises sharply, but drops again significantly during the subsequent kilning process. What is the general water content of the finished malt?
a) Between 10 % and 11
b) Between 7 % and 8 %
c) Between 4 % and 5 %
d) Between 1 % and 2 %
e) Between 0 % and 1 %
2. During a malt analysis, the viscosity is also determined, among other things. This value mainly indicates...
a) the subsequent behavior of the wort during lautering and the filterability of the beer.
b) …the Kolbach index.
c) …the glassiness of the malt.
d) …the expected boiling time.
e) …the water content of the malt.
3. FAN is the abbreviation for free amino nitrogen. This value mainly provides information on...
a) …the total amount of nitrogen that has gone into solution from the malt.
b) …the protein content of the malt.
c) …the amylolytic solution of the malt.
d) …the viscosity of the wort.
e) …the compounds in the malt that are important for yeast nutrition.
4. The different basic tastes are perceived by the taste buds on the tongue. Which of the following taste sensations does not (typically) play a role when tasting beer?
a) Sweet b) Salty
c) Bitterness d) Sour
e) Umami
5. Which taste impression is created by the off-flavor "DMS" (dimethyl sulfide)?
a) Green apple
b) Cooked vegetables, cabbage-like
c) Banana flavor
d) Butter aroma
e) Blackcurrant aroma
6. During mashing, water-insoluble components of the malt are converted into water-soluble components. The conversion of insoluble starch into soluble sugars is particularly important. Starch consists of:
a) Amylose and amylase.
b) Amylose and maltose.
c) Amylose and amylopectin.
d) Amylase and amylopectin.
e) Amylose and atropine.
7. The breakdown of starch during mashing begins with gelatinization. What happens during this process?
a) Hydrogen bonds form between the starch chains.
b) Water penetrates the starch granules, which then swell and burst.
c) The starch coagulates at temperatures above 50 °C.
d) The sugar molecules surrounding the starch bind water and thus gelatinize.
e) The sugar molecules at the ends of the starch chains clump together.
8. A brewery carries out very intensive aeration of the pitching wort in the cooling room. What effect does this have?
a) The final degree of fermentation remains low.
b) Fermentation starts more slowly.
c) The multiplication of the pitching yeast is accelerated.
d) Only a few fermentation by-products are produced during fermentation.
e) The beer taste is positively influenced.
9. During wort boiling, the pH of the wort also drops slightly but measurably. What are the main causes of this? (2 options are correct)
a) The overpressure during boiling in the closed system.
b) The removal of the precipitated protein.
c) The formation of melanoidins during the boiling process.
d) The dissolution of hop ingredients.
e) The high heat input during the boiling.
10. When filling beverages with a pH value of less than 4.5, there is no risk of the product being contaminated with pathogenic germs. Which of the beverages listed has the highest pH value?
a) Tap water
b) Energy drinks
c) Orange juice
d) Soft drinks
e) Beer
1. c) During kilning, the water content in the grains is reduced from more than 40 % to less than 5 %. This stops the vital functions in the malt such as germination, dissolution, and other enzyme activities. This ensures the storability and shelf life of the malt. A further reduction in the water content costs more energy and could also damage the enzymes formed in the malt because of the longer exposure time.
2. a) The chemical and technical analysis of malt is usually carried out using the Congress mashing method. A wort is produced from a malt sample (50 g) in the laboratory according to a standardized procedure and then analyzed for various parameters. This also includes viscosity. The wort viscosity provides information on the future behavior of the process wort during lautering and about beer filtration. The viscosity of the Congress wort should not be higher than 1.5-1.6 mPa·s. Full beer with an original gravity of 12 % has a viscosity in the range of 1.6-2 mPa·s.
3. e) Amino acids are of great importance for yeast nutrition. Yeast consumes at least 10-14 mg of free amino nitrogen (FAN) per 100 mL wort. The better modified the malt is, the more FAN is formed during the mashing at 45-50 °C. Wort with sufficient FAN is always obtained from well modified malt. If adjuncts, sugar, or syrup are also used, however, these introduce no or little amino acids to the wort and an additional (amino acid) rest at 45°C is recommended.
4. e) The human tongue contains receptors for the five basic tastes: sweet, salty, sour, bitter and umami. All our taste perceptions are a combination of these five impressions. The overall flavor impression is complemented by the aroma, for which there are many more receptors in the nose. Umami is a savory, meaty taste sensation and plays only a minor role in beer.
5. b) Dimethyl sulfide (DMS) is responsible for causing a cooked corn-, vegetable-, or cabbage-like flavor impression in the beer. Malt already contains the precursors of DMS that are converted into DMS by heat. This happens during kilning and continues during wort boiling. Since dimethyl sulfide is a volatile substance, it can be evaporated during wort boiling. It is, however, essential to ensure that dimethyl sulfide does not continue to be formed later in the whirlpool. This cannot be evaporated anymore and therefore creates a significant off-flavor.
6. c) Starch is the most important constituent of barley and makes up 63 % of the barley dry matter. Barley starch consists mainly of two different types of starch: amylose and amylopectin. Amylose (about 20 %) consists of long, unbranched helical chains and contains up to 2000 glucose molecules, which are arranged in helical spirals. Amylopectin is the main component of the starch granules (about 80%). The amylopectin molecules are branched and about 10 times larger than amylose molecules (up to 40,000 glucose molecules). Amylopectin has the appearance of a branched tree, with many clusters of glucose chains branching from the trunk.
7. b) During gelatinization, water molecules bind to the starch chains at higher temperatures. This leads to an increase in volume, which causes the starch granules to swell and eventually burst. The result is an increasingly viscous aqueous solution. The gelatinization temperatures of most types of grain are between 65 and 80 °C. Malt starch normally begins to gelatinize at 59-61 °C. This is a physical, not enzymatic, process, and no substance degradation takes place at this stage. However, complete gelatinization is a prerequisite for the complete breakdown of starch by the amylases during mashing.
8. c) Yeast needs oxygen for cell proliferation, especially for the synthesis of fatty acids. These fatty acids are the main components of the cell membranes. To ensure rapid multiplication of the pitching yeast and thus rapid initial fermentation, the wort is aerated after cooling. The oxygen contained in this sterile compressed air is consumed by the yeast cells within a few hours due to the strong cell proliferation. However, too intensive aeration can also have a negative effect on wort quality. The optimum aeration rate depends on the fermentation process. For open fermentation processes, 8-9 mg O2/l is recommended, while 4.5-6 mg O2/l is usually sufficient for closed fermentation in a cylindroconical tank (CCT).
9. c) During the boiling of the wort, the pH of the full -kettle wort drops from 5.5-5.6 to 5.4-5.5 in the casting wort. The main reasons for this are the formation of melanoidins and the added hop ingredients. Melanoidins are colorants and flavor substances that are formed from sugars and amino acids at temperatures of more than 90 °C. This mainly occurs during kilning of the malt, but also during wort boiling. Melanoidins have an acidic effect in aqueous solution, i.e., they lower the pH. In addition, the alpha and beta acids added via the hops also contribute to lowering the pH.
10. a) Soft drinks, cola, and energy drinks contain acids (e.g. citric acid, phosphoric acid) and therefore have a relatively low pH of between 2.5 and 3.5. The pH of fruit juices is between 2.5 and 4.0, depending on the fruit (e.g. apple or orange juice approximately 3.5). Beer has a pH between 4.1 and 4.6 (exception: sour beers 3.0-3.5). The pH of water varies between 6.5-9.0 but is generally around 7.0 (neutral).


1) Charlene Louw, Managing Director of the Beer Association of South Africa (BASA), reported on the challenges of the South African beer market
The 5th VLB Africa Brewing Conference took place in Johannesburg, South Africa, from June 2 to 4, 2025. Following previous events in Ethiopia (2019), and Cameroon (2023), and two online editions, the conference once again served as an important meeting place for the African brewing industry.
(oh) Around 130 participants from various countries took advantage of the opportunity to engage in indepth discussions, further training, and networking. Charlene Louw, Managing Director of the Beer Association of South Africa (BASA), and Christopher Day from market researcher Euromonitor International opened the event with valuable insights into the South African beer market. While many regions around the world are experiencing a decline in beer consumption, Africa continues to be a growth market, with South Africa at the forefront. Per capita consumption there is around 60 liters per year, with total production of around 40 million hectoliters of beer. The market is dominated by AB InBev (South African Breweries, SAB) and Heineken. In addition, United Breweries (formerly Diageo, which mainly produces sorghum beer), several medium-sized brewers and about 200 craft breweries are competing for consumer attention.

Approximately 75% of beer is consumed in urban areas. Lager is by far the most popular type, followed by stout and dark beer. The brewing industry also makes a significant contribution to the economy: in addition to approximately USD 5.2 billion in taxes, around 210,000 jobs in upstream and downstream sectors (agriculture, catering, and retail) depend on the brewing industry. This is a significant factor in a country facing
high unemployment. According to BASA, the industry’s biggest current challenges include high taxes, increasingly stringent regulations, growing water and energy short-
ages, and widespread smuggling and illicit alcohol production. Market research institute Euromonitor International forecasts further growth for the African beer market in terms of both volume and revenue. Non-alcoholic beers present particularly attractive growth opportunities. The rapid spread of smartphones in Africa also creates significant potential for digital so -
lutions across the supply chain, in hospitality, and in consumer engagement. The young, innovationfriendly population will increasingly shape the market, but it also has demands: they want innovative beverages, show less brand loyalty, and have different preferences from traditional beer drinkers. The rest of the conference focused on brewing technology topics, covering topics such as raw materials (brewing grains, water, hops), sustainability, yeast and fermentation technology, and modern filling and packaging solutions. The supporting program included tours of the Alrode Brewery (AB InBev) and the Sedibeng Brewery (Heineken), providing unique insights into two of South Africa’s largest breweries. Lively discussions and a convivial evening at Gilroy’s Pub Brewery rounded off the VLB Africa Brewing Conference 2025.
The next VLB Africa Brewing Conference is scheduled for 2027.





Ponta Grossa, Brazil, 10 to 12 November 2025
+ Latin American beer markets, consumer preferences and trends
+ Raw materials: Barley, malt, adjuncts, hops
+ Brewhouse, fermentation & filtration: Current issues
+ Brewing process: Innovations and improvements in the brewing process
+ Non-alcoholic beer in Brazil
+ Filling and packaging of beer and beverages
Technical visits to Agrária-Malteria Campos Gerais and Ambev.
Additional workshops on sensory evaluation and packaging on November 13.
This symposium will be held in English and Portuguese with simultaneous translation







Ambev +++ Agrária & Malteria Campos Gerais +++ Coca Cola Andina +++ Brauwelt International +++
Happy sensory experts after a successful evaluation:
The authorized inspectors were also very satisfied, including Dr. Martin Zarnkow
and Ludmila
For 50 years, the International Quality Test for Beer of the Deutsche Landwirtschafts-Gesellschaft (German Agricultural Society, DLG) has been a benchmark for the outstanding quality of beers brewed in accordance with the German Reinheitsgebot (purity law). The analytical and sensory evaluation of the samples is carried out by experts from the VLB Berlin and the Weihenstephan Research Center for Brewing and Food Quality (BLQ).
(BF) Since the quality test was introduced in 1975, more than 60,000 beers have been tested by experts in Berlin and Weihenstephan on behalf of the DLG. To ensure that both tasting teams apply the DLG 5-Point Scheme® for beer in the same way, a joint sensory seminar is held once a year. “The aim is to ensure the reproducibility and objectivity of our test results,” explained Thomas Burkhardt, DLG project manager for beverages This year, the sensory seminar took place on July 10 at the VLB in Berlin. Together, about 30 sensory experts from Berlin and Weihenstephan evaluated beer samples using the descriptive sensory DLG analysis. These included Pilsner, Export, wheat beer, Kölsch, Bock, and alcohol-free beer. This involves
evaluating and discussing whether the respective product is typical of its beer type in terms of its aroma and flavor characteristics. Since sensory tests are always attribute tests, i.e. in addition to identifying sensory deviations, a consistent verbal description of the defect is also crucial. For this reason, the DLG technical vocabulary and sensory descriptors are also reviewed and trained in their use at these joint seminars. These descriptors are then included in the DLG 5-Point Scheme ® and in the specialist publication “DLG Sensory Vocabulary”.
“The tasting results highlight the professionalism of our tasters and thus the high informational value of the DLG test results. Regular reviews of good testing
practice through DLG alignment seminars are important to maintain high standards and, when necessary, to further develop them together,” agree the two DLG test representatives for beer, Ludmila Linke (VLB Berlin) and Dr. Martin Zarnkow (Weihenstephan Research Centre for Brewing and Food Quality).
The International DLG Food Test for Beer, Craft Beer, and Beer-Mixed Drinks takes place twice a year. Registration is always open in May and August. In addition to the sensory evaluation, each submitted sample also undergoes laboratory beer analysis, and its biological shelf life is tested.. Further information is available at www.dlgtestservice.com/en/food/foodtesting/beer.

This Interview was conducted by Michaela Knoer, librarian of VLB's Axel Simon Library
Tianxiao Xu from China deepened his love and knowledge of beer by taking the Certified Brewmaster course at VLB Berlin. After returning to China, he plans to pass on his expertise to brewers and to open a small craft brewery himself. China is a huge beer market with curious and consumption-oriented people who appreciate good beer – especially the craft beer market is booming at the moment.

Michaela Knoer (MK): How did you first come into contact with beer and why did you decide to become a brewer?
Tianxiao Xu (TX): My relationship with craft beer began in 2019. A friend gave me a beer to drink that I thought was the most bitter beer I had ever tasted – Dogfish Head 60 Minute IPA. And then there was Belching Beaver Peanut Butter Milk Stout. It was only then that I realized, beer could have such a wide variety of flavors. After that, I bought many books on craft beer and the BJCP (Beer Judge Certification Program) and began to learn. Later, I obtained the BJCP certificate and worked as a judge at the “Master Cup China Beer Tournament.”
I studied Automated Logistics at Shandong University in Qingdao. I had originally planned to go to Germany after graduating in 2020
in order to study for a Master's Degree in Mechanical Engineering and Automation. But because of the pandemic, I stayed in China and worked here. The boring programming work made me unhappy, so I started brewing beer at home. When I drank my first home brewed beer, I knew I had found what I wanted to do in life.
I quit my job and started working at the top Chinese brewery Ye Brewing, where I was responsible for product development and created small batches of new beers. In 2023, our stout from Ye Brewing won the Gold Award at the European Beer Star competition. I traveled to Germany to accept the award and had the opportunity to visit many breweries in Europe. This experience reawakened my “dream of studying in Germany.” If I wanted to pursue brewing as a future career, I needed to learn it systematically. At the same time, I taught myself German and passed the C1 exam. On the recommendation of a friend, I learned about the VLB Certified Brewmaster course.
MK: How would you describe the beer market and taste in China?
TX: The Chinese beer market is the largest and most diverse in the world, dominated by light lager –refreshing, low in bitterness, and perfect with Chinese food. Local brands such as Snow Beer, Tsingtao, and Yanjing have the largest market share, while international brands such as Budweiser and Heineken focus on the premium market. In recent years, craft beer and niche brands have become more popular, with varieties such as IPA, stout, and fruit beer. Consumers increasingly prefer high-quality and indi -
vidual products instead of cheap mass-produced goods – the trend is clearly moving towards premium.
MK: And who drinks beer in China? How expensive is beer in stores and in restaurants?
TX: In China, consumer groups and prices for beer vary depending on the scene. About 80 % of men prefer industrial beer, while craft beer is mainly consumed by young people between the ages of 20 and 40.
A glass of this type of craft beer costs the equivalent of about 6 € in China
Roasted Malt Beers
Malt Extracts
Beer Concentrate
Brewing Syrups
Caramel
Liquid Sugar
ASPERA BRAUEREI RIESE GMBH
45478 Muelheim-Ruhr, Germany
Phone +49 208 58 89 80 / aspera@aspera-riese.de www.aspera.de

Of these young consumers, young women make up 60 % of the craft beer market. As for prices, a regular beer costs about 1 US-$ per bottle in supermarkets or restaurants. However, if you go to a bar and order craft beer, the price per glass is about 5 to 10 US-$. Imported beers are even more expensive. Some American IPAs can cost up to 15 to 20 US-$ per glass.

In August, Tianxiao Xu was busy renovating his new brewpub (120 m2), which is located in Leshan.
The pub is called „The other shore“ which is the name of the flower in the logo
MK: What is the legal situation for beer. Do you pay taxes homebrewing and microbrewing in China?
TX: The laws in China regarding homebrewing have not yet been fully developed. You are allowed to brew beer at home and drink it or give it to friends, but it does not seem to be permitted to sell it. Small brewpubs can only sell beer they have produced themselves. They cannot resell the beer to other cities. I am not very familiar with the tax situation. Unlike in Germany, where restaurants are subject to a 19 % sales tax and many products in supermarkets are subject to at least 7 % tax, there is no such tax in China.
MK: How is beer mainly packaged in China: in bottles, cans, or kegs? Are there returnable bottles?
TX: Large industrial breweries such as Tsingtao mainly use green glass bottles to bottle their beer and account for about 95 % of the market share. Of course, these glass bottles are reused repeatedly. Craft breweries mainly fill their beer in 20-liter
kegs, while a few craft breweries also use cans.
MK: Is craft beer common?
TX: There are currently hundreds of craft beer brands in China – and those are just the best-known ones. There are many more small local breweries. The development of the craft beer market in China is currently breathtaking. Every major city now has over 100 bars offering craft beer, and dozens of craft beer festivals are held in China every year.
MK: What is your favorite type of beer? And what type of beer is popular in China?
TX: My favorite styles are the following: 1. English Bitters, which highlight the balanced flavors of malt and hops. 2. Black Beer, which is full of chocolate aroma and very dry at the same time. 3. Sour IPA, where the tropical fruits brought by the hops are well combined with the taste of lactic acid. 4. Italian Grape Ale, a perfect blend of wine and beer.
In China, German Bavarian Wheat Beer is the most popular among mass consumers, and Chinese people particularly love German beer because they believe in the “Reinheitsgebot” (purity law). Craft beer consumers prefer to drink hazy IPAs and fruit sour beers.
MK: When you came to Berlin, what struck you most in terms of beer?
TX: Here in Berlin, it was of course Berliner Weisse, a type of beer that is unique to the Berlin region. I didn't know that Berliner Weisse had traditionally used Brettanomyces in fermentation in the past before I took the VLB courses. In Berlin, I saw that Berliner Kindl Weisse with green and red syrup was very popular in Berlin, but I preferred the beers from the local Schneeeule Brewery, where I drank pure
traditional Berliner Weisse for the first time, served with “Kümmel Schnaps” (caraway spirit), which also tasted very interesting. I think the most attractive aspect is the beer style and culture of different countries and regions. I go to Belgian breweries to drink Lambic, to Italy to find local Italian grape ale, to Poland to drink authentic Polish smoked beer (Grodziskie), to Pilsen to visit and drink Pilsner Urquell, and of course, German beer is even more appealing. Bamberg drinks Rauchbier, Leipzig Gose, Cologne Kölsch. In the past, traveling may have been all about taking photos at the sights, but if you like craft beer, beer tours become even more interesting.
MK: Why did you decide to come to VLB, and what was your most memorable experience during the course?
TX: There are several well-known beer brewing schools around the world, and after doing some research, I found that the VLB curriculum is the most comprehensive in terms of theoretical knowledge. I had already brewed a lot of beer, but I had never received systematic training.
One of the most memorable experiences for me was when we brewed beer in a brewing museum in Thuringia using equipment from hundreds of years ago. As a gypsy brewer and promoter of home breweries, I have used many large and small kinds of brewing equipment, but this was the first time I had done it in such a primitive, traditional way. In the brewery, which dates back to 1734, the mash in a



1,000-liter wooden mash tun must be stirred by hand. It is heated by boiling using a traditional mash method, heated by direct fire, cooled overnight in a coolship, and placed in an open wooden fermentation tank with yeast borrowed from other nearby breweries. This beautiful little village, where brewing and barbecuing took place (at the Open Air Museum at Vessra Monastery), left me with pleasant memories.
MK: What is the advantage of studying on-site in Berlin?
TX: I think the most important thing is to communicate with each other face to face. The CBC 2025 had 25 students from 16 countries, all with different cultural backgrounds and brewing experiences. Amani from Kenya introduced us to the brewing process of sorghum beer in Africa and gave us a tasting, Peter from Canada brought us craft beer from his family brewery, Mikko from Finland has published six books on beer and whiskey, and he also brought a kvass beer fermented with bread. These are all special experi -
ences you only get in person. The VLB laboratory is also very informative, and I learned a lot about the CTA testing and microbiology laboratories.
MK: In your opinion, what are the advantages of the VLB Berlin CBC course as a whole?
TX: The advantage of the CBC course is that it teaches you malting and brewing techniques in a systematic way. After completing the course you can work as a brewer, but also in a malting plant or for an equipment manufacturer. You learn a lot about the basics of various equipment used in the entire beer brewing process, which is very helpful for your professional development. Finally, I would like to say that the biggest advantage of this course is having “Captain” Burghard Meyer as course instructor and teacher. As a traditional German brewer, who started his career as a brewer apprentice and then studied Brewing Technology, he has extensive experience in both theory and practice. But I am also grateful to all the other teachers of the course. They all told us that even after the course, we can send them emails to ask questions if we encounter brewing-related problems at work that we don't know how to solve.
MK: Back in China, how can you use your knowledge and what would you like to work on next?
TX: Before I went to Germany, I was responsible for the Homebrew Beer project at the Beijing Homebrew Society, where I taught others how to brew beer at home. After graduating from the VLB, I plan to pass on what I have learned to professional brewers in China so that they can improve their beermaking skills. As for my career, I will set up a new brewery and brew a few craft beers. Maybe one day I will come back to Berlin with my beer and share it with everyone at the VLB Guild House.
Smarter denoising of X-ray shots. Deeper analysis of camera images. Clever differentiation between good and bad:
Our deep learning AI makes not only the pulsed X-ray inspection for glass-in-glass detection even more intelligent. But now also the optical empty bottle inspection with the HEUFT InLine II IX
Deep learning empty bottle inspection with HEUFT reflexx A.I.. Detection reliability up! False rejections down! For your benefit.



ll our training courses take place in our pilot brewery and highly specialized laboratories
Since its foundation in 1883, VLB has also been a brewing school. VLB supports the regular study programs for brewers at Technische Universität Berlin. Furthermore, it provides continuous training in the field of beer brewing and beverage technology – in German and English. In addition, ‘Brewing in a Nutshell’ is offered as an on-demand online course.
The VLB’s flagship training course for prospective brewers is a sixmonth full-time program that provides in-depth understanding of brewing technology covering related major fields such as engineering, filling and packaging, and quality control. The Certified Brewmaster Course 2025 will be held as a complete classroom event. This means that the theoretical and practical work will alternate over the six months of the training. The Berlin brewmaster education is focused on a comprehensive, practice-oriented knowledge transfer, knowledge transfer, open dialog with the lecturers, and networking on an international basis.
To receive the VLB Brewmaster Certificate, the graduates have to successfully complete the course and all exams. In addition, they have to prove a minimum of three months of practical work in a brewery before coming to the VLB. A reasonable group size for practical work guarantees an intensive and individual teaching.
Location: Berlin, Germany
Next date:
7 January – 26 June 2026
More information: www.vlb-berlin.org/en/cbc2026
Applied Microbiology is a oneweek full-time training course providing up-to-date knowledge in the field of practical microbiology relevant for the brewing and
beverage industry. It covers the basics of microbiology, laboratory techniques as well as microbial sampling in theory and practice. The course is conducted in the VLB’s microbiological training laboratory and in the VLB pilot brewery.
Location:
Berlin, Germany
Next date: 17 – 21 November 2025
More information: www.vlb-berlin.org/en/ microbiology2025
Beer Brewing in Practice is a ten-day, full-time course that provides up-to-date knowledge of brewing. It covers the fundamentals of brewing in theory and practice. Lectures by experienced brewing experts cover topics such as raw materials (water, malt, hops, and yeast), the brewing process, yeast management, fermentation, hygiene, sensory evaluation, the basics of quality control and the economic and legal aspects of setting up a brewery.

The course is taught in English. Starting with a practical brewing session on the first day, participants will follow a brew from start to finish, including practical quality control.
Location: Berlin, Germany
Next date: 16 – 27 November 2026
More information: www.vlb-berlin.org/en/ beerbrewing2026
This on-demand online course covers the basics of beer brewing. It approaches the general principles of the brewing and malting processes, the raw materials as well as filling and packaging in theory. Participant receive a Certificate of Attendance.
Location: Online on-demand
Next date:
Anytime throughout the year
More information: www.vlb-berlin.org/en/bianso
On June 27, 2025, once again the time had come: 24 graduates received their certificates during a festive ceremony. Dr. Josef Fontaine, in his last appearance as VLB managing director, praised the participants' accomplishments and thanked everyone involved for their remarkable commitment.
(ew) VLB Managing Director Dr. Josef Fontaine opened the graduation ceremony with a speech to the graduates and their families and friends, some of whom traveled from afar to attend. “You have completed this course with great dedication. The certificates you are receiving today are well deserved.” Burghard Meyer also praised the participants' achievements. “This year, the class cohesion was exceptionally good, which was also reflected in the final grades,” said the course instructor. The best in the class was Natália Basso Tolazzi from Heineken Brazil. Ahmet Tanir (Anadolu Efes, Turkey) came in second, and Maria Jose Garcia Vela from Mahou-San Miguel in Spain came in third.
As every year, one graduate received a gift on behalf of the class. This time, Luca Ferrari received a pewter mug from the course instructor's personal collection. The reason for this honor: Luca had been exceptionally reliable. A special highlight of the ceremony was
the speech by Finnish participant Mikko Salmi, who eloquently and humorously reviewed the past six months. At the end of his speech, many people reached for their handkerchiefs. Once the tears of emotion had dried, the informal part of the farewell began.
We were delighted and thankful for the positive feedback we received this year. Here are a few quotes from participants from their social media channels: “It was a very intense and challenging 6 months. This course required countless hours of studying, reading, research, and sleepless nights. I made so many great friends, memories, and connections in the industry that made it all worth it.
I’m so excited to use my new found knowledge to make outstanding beer and continue to advance my understanding. Thank you to everyone involved”. (Peter Bulut, III)
“A very special thank you to Burghard Meyer for his valuable
guidance and support during the course.” (Topçuoğlu, Gamze)
This six-month journey was not only technical training, but also a unique cultural and personal experience. During my time in Germany, I had the chance to meet and collaborate with professionals from all around the world, which enriched my perspective both personally and professionally. I am also deeply thankful to VLB Berlin and all my lecturers for their dedication and the excellent education they provided.” (Ünveren Kizilgök, Pelin)
“These six months in Berlin gave me far more than just a certificate. I had the chance to meet 28 people from over 15 countries, learn about their cultures, and build valuable connections that I hope to keep in the future. (...) I feel fortunate to have had this experience” (Ahmet Tanir).
VLB would like to thank all participants for their efforts and valuable contributions. Thanks for being with us!

The VLB Certified Brewmaster Course 2025 was special: The cohesion between the students was remarkably strong and warm-hearted. Correspondignly, everyone was sad that the six months in Berlin had come to an end

Hard work pays off: 24 graduates from 16 different nations received their certificates at the end of June 2025. One participant dropped out earlier and did not finish the course. VLB Berlin congratulates all participants on successfully completing the demanding Certified Brewmaster Course
























Group photo in the atrium of the VLB: Participants in the meeting, including (left) the new First Chairman Burghard Meyer, kneeling in the middle: the outgoing and newly re-elected Second Managing Chairman, Jan Biering, the two cash auditors
Jürgen Solkowski (third from right, standing) and Manfred Staruß (fourth from right, standing)
The 2025 annual General Meeting of the Vereinigung ehem. VLBer e.V. / Brewers of Berlin (VLB alumni association) took place in Berlin on 4 July, 2025, ahead of the VLB summer party. A newly elected board, a new honorary member, continued support for the renovation of the guild house, and an increase in membership fees were the core topics of the meeting.
(oh) As the First Chairman, Klaus Niemsch, had to cancel his participation at short notice for health reasons, the Second Chairman, Jan Biering, took over as chair of the meeting.
First, a moment of silence was held for the association members who had passed away since July 2024:
Bauer, Otto (30 April, 25)
Gürtler, Franz (16 August, 24)
Hammerl, Bernd (17 May, 25)
Klostermann, Norbert (2 June, 25)
Dr. Neumann, Lothar (13 December, 24)
Pott, Rainer (2 February, 25)
Dr. Rinke Wilfried, honorary member (21 March, 25)
Rolf Schorn (23 April, 25)
Schoknecht, Klaus (5 December, 24)
Splett, Erich (13 August, 24)
Strunkeit, Joachim (22 July, 24)
von Gößnitz, Gerhard (27 July, 24)
Wührer, Richard (6 July 24)
During the reporting period, there were seven new admissions (four of which were 10-year long-term memberships), three resignations, ten expulsions due to long-term non-payment of membership fees, and 13 deaths.
This was followed by the 2nd Chairman's report on the activities of the association in the past year. There were three international alumni meetings: Bangalore, India (4 September, 2024), Shanghai, China (30 October, 2024), and Indianapolis, USA (30 April, 2025), as well as meetings of the Bavaria and Austria district groups (Krügl, 16–18 May, 2025, in Schongau) and North Rhine-Westphalia (Klepczynski, 24 April, 2025, in Dortmund).
Burghard Meyer reported on the status of the dissolution of the Berlin Brewers' Guild. The association is no longer active, but has not yet been formally dissolved. A tax assessment from the tax office is still

Vereinigung ehem. VLBer e.V. – Brewers of Berlin
1st Chairman:
Burghard Meyer (Berlin)
2nd Chairman (executive): Jan Biering (Berlin)
Contact:
Seestraße 13, 13353 Berlin ehemvlber@vlb-berlin.org www.vlb-berlin.org/ ehemvlber
Information on membership:
required for the necessary cash settlement. Once this matter has been clarified, the Berlin Brewers' Guild can be deleted from the register of associations.
Meyer also reported on the latest developments at the guild house on the VLB premises. The guild house was closed for several weeks in September 2024 due to structural defects. After these were provisionally repaired, the building has been in use again as usual since October 2024. A master's thesis in the field of historical building research and monument preservation at the Technical University of Berlin is to begin shortly to plan the further refurbishment of the guild house. The aim is to survey the building using modern methods and examine it using modern building research
techniques. The resulting documents and findings can then serve as a basis for the further renovation of the guild house. This work will be free of charge for the VLB and the association.
Biering presented the cash report for the 2024 calendar year. This was audited by the two cash auditors, Jürgen Solkowski and Manfred Staruß, on21 May, 2025, at the VLB and approved without objection. Revenue from membership fees rose slightly to around €6,200. This was offset by expenses for administration and member services amounting to around €7,000. These include expenses for district group meetings, hospitality costs for international alumni gatherings, and financial support for the VLB summer party in 2024. The association's assets therefore decreased minimally by around €800.
Josef Fontaine moved to discharge the old board. The general meeting approved this motion unanimously.
The previous First Chairman, Klaus Niemsch, had already announced at the 2024 General Meeting that he did not intend to stand for re-election after more than 30 years. The General Meeting voted in favor of the election proposal published in the agenda, with one abstention recorded. Since 4 July, 2025, the new board has been composed as follows:
First Chairman: Burghard Meyer (Berlin)
Second Chairman (executive) : Jan Biering (Berlin)
Treasurer: Financial Accounting Department of VLB Berlin
Auditors: Manfred Staruß (Berlin) and Jürgen Solkowski (Potsdam)
The former First Chairman, Klaus Niemsch, announced he would not seek re-election, „was unable to attend but sent his apologies, had asked in advance for his greetings to be conveyed to the General Meeting: “I would like to thank the members for their decades of trust and the executive chairmen for their consistently smooth cooperation. I would also like to thank Dr. Fontaine for always being open to the concerns of the association and Olaf Hendel for ensuring an appropriate presence in the Brauerei Forum.”
Honorary membership for Klaus Niemsch
In recognition of Klaus Niemsch's continuous service as honorary chairman of the association since 1994, the General
Meeting awarded him honorary membership. As he was not present, the corresponding recognition will be presented at the VLB stand at drinktec in Munich (Tuesday, 16 September, 11:00 a.m., VLB stand Hall C3, 122).
The question of whether the current annual membership fee should be increased was already raised at the 2024 general meeting. The discussion on this was postponed to the 2025 general meeting. After the association's annual membership fee was last increased in 2001 from DM 20 to €15, the general meeting, following intensive discussion, accepted the board's proposal to increase this fee to €30 per year effective 1 January, 2026. Although this represents a nominal increase of 100 %, it is not excessive and is justifiable in view of the still reasonable amount and also in direct comparison with the membership fees of similar associations. As further renovation measures are necessary, particularly at the guild house as a meeting place for students and alumni at the Seestraße location that fosters a sense of identity, further support from former VLBer members is desirable and in accordance with the statutes. In order for this to continue to be possible without depleting the association's cash reserves too much, an increase in the annual membership fee is unavoidable, according to the general consensus of the members present.
After thorough discussion, the general meeting approved further financial support for the renovation measures of the guild house. The next steps are to reinforce the steel framework of the building and to install the sanitary container purchased by the VLB beneath the building. This work is to be commissioned after the upcoming building inspection and survey have been completed. To ensure that this work can then begin without further delay, the general meeting (with one dissenting vote) approved a budget of 15,000 € for the board to carry out urgently needed maintenance work, including the installation of sanitary facilities at the guild house.
The next General Meeting is scheduled to take place again before the VLB summer party (expected on July 3, 2026, in Berlin).
The complete minutes of the meeting are available to all members of the Association of ehem. VLBer/Brewers of Berlin upon request: ehemvlber@vlb-berlin.org
Technical periodical for breweries, malthouses, the beverage industry and their partners
Information service of VLB Berlin www.brauerei-forum.de
ISSN 0179–2466
Publisher
Versuchs- und Lehranstalt für Brauerei in Berlin (VLB) e.V. Seestrasse 13, 13353 Berlin, Germany
Editorial Office
Brauerei Forum
Seestrasse 13, 13353 Berlin, Germany
Phone: + 49 (30) 4 50 80-251
Fax: + 49 (30) 4 50 80-210
Email: redaktion@brauerei-forum.de Internet: www.brauerei-forum.de
Editorial Department
Olaf Hendel, Editor-in-Chief (oh) hendel@vlb-berlin.org
Eva Wiesgrill (ew) e.wiesgrill@vlb-berlin.org
Julia Bork (jb), j.bork@vlb-berlin.org
Brauerei Forum Advisory Board
Dr.-Ing. Josef Fontaine, Dr. sc. techn. Hans-J. Manger
Advertising Sales
VLB PR and Publishing Department
Phone +49 (30) 450 80-255 media@brauerei-forum.de
Publication Dates
Appears with 8 editions a year, in German plus 2 issues in English.
Subscriptions
Domestic 95 € incl. VAT
Abroad 95 € (+ shipping)
Cancellation of the subscription in each case at the end of the year Westkreuz Verlag, Berlin
Phone +49 (30) 7 45 20 47
Fax +49 (30) 745 30 66 abo@brauerei-forum.de
Print and Distribution
Westkreuz Verlag GmbH
Töpchiner Weg 198/200 12309 Berlin, Germany
All rights reserved. No part of this publication may be reproduced in any form without the prior written permission of VLB Berlin. We do not accept any liability of unsolicited sended scripts. The editor do not assume any responsibility for contributions marked with a name or signature.
Our next German edition will be released on 6 October 2025
The next international edition will be released in May 2026
editor@brauerei-forum.de
www.brauerei-forum.de
VLB October Convention 2025 6/7 October 2025, Berlin
General Assembly VLB Berlin 6 October 2025, Berlin
15th Ibero-American VLB Symposium 2025, incl. Sensory and Packaging Workshops
10 to 13 November 2025, Parana, Brasilien
Training Applied Microbiology 2025 17 to 21 November 2025, Berlin
VLB Certified Brewmaster Course 2026 7 January to 26 June 2026, Berlin
110 th VLB Brewing & Engineering Conference 2026 24 to 26 March 2026, Erding, Germany
5th VLB Symposium on Acidic Fermented Non-Alcoholic Beverages 12-13 May 2026, Berlin

Bangkok Brewing Conference June 2026, Bangkok, Thailand
Workshop “Beer Brewing in Practice” 1 to 12 September 2025, Berlin
North American VLB Brewing & Packaging Conference 2026 14-18 September 2026, Toronto, Canada
Ibero-American VLB Symposium 2026 16-19 November 2026, Panama



